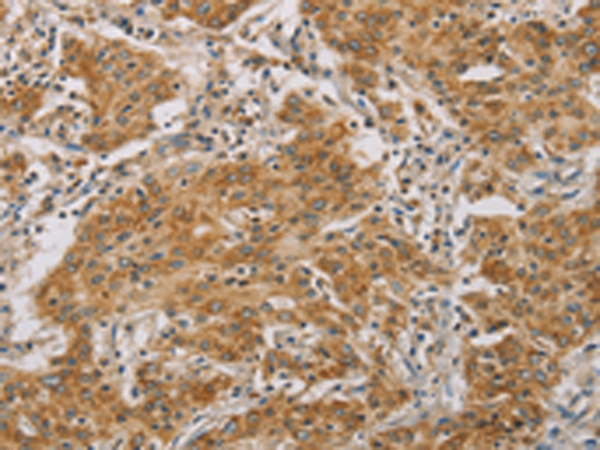

中文名稱:兔抗CDKN2A多克隆抗體
英文名稱: Anti-CDKN2A rabbit polyclonal antibody
別 名: ARF; MLM; P14; P16; P19; CMM2; INK4; MTS1; TP16; CDK4I; CDKN2; INK4A; MTS-1; P14ARF; P19ARF; P16INK4; P16INK4A; P16-INK4A
相關類別: 一抗
儲 存: 冷凍(-20℃)
宿 主: Rabbit
抗 原: CDKN2A
標 記 物: Unconjugate
克隆類型: rabbit polyclonal
技術規(guī)格
|
Background: |
This gene generates several transcript variants which differ in their first exons. At least three alternatively spliced variants encoding distinct proteins have been reported, two of which encode structurally related isoforms known to function as inhibitors of CDK4 kinase. The remaining transcript includes an alternate first exon located 20 Kb upstream of the remainder of the gene; this transcript contains an alternate open reading frame (ARF) that specifies a protein which is structurally unrelated to the products of the other variants. This ARF product functions as a stabilizer of the tumor suppressor protein p53 as it can interact with, and sequester, the E3 ubiquitin-protein ligase MDM2, a protein responsible for the degradation of p53. |
|
Applications: |
ELISA, IHC |
|
Name of antibody: |
CDKN2A |
|
Immunogen: |
Synthetic peptide of human CDKN2A |
|
Full name: |
cyclin-dependent kinase inhibitor 2A |
|
Synonyms: |
ARF; MLM; P14; P16; P19; CMM2; INK4; MTS1; TP16; CDK4I; CDKN2; INK4A; MTS-1; P14ARF; P19ARF; P16INK4; P16INK4A; P16-INK4A |
|
SwissProt: |
P42771 |
|
IHC positive control: |
Human gastric cancer and human thyroid cancer |
|
IHC Recommend dilution: |
50-200 |
購物車
幫助
021-54845833/15800441009
